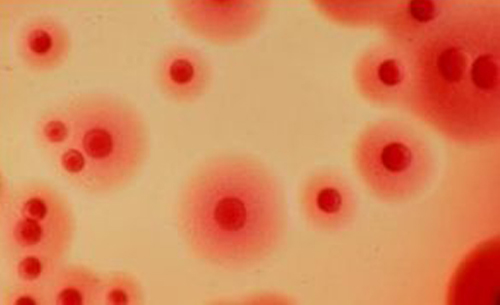
梅毒的早期症状（梅毒的早期症状有哪些）

梅毒是男女性相互感染的常见性病之一,主要是由于性生活不洁净男女之间互相感染引起的,那么梅毒的早期症状有哪些了,这里给大家介绍下。
下疳症状
梅毒螺旋体进入人体2-3周后,在初次进入皮肤或粘膜的部位就会出现下疳,下疳是梅毒早期临床症状之一。所谓下疳就是指发生于男女性外生殖器体表的化脓性感染性疾病。男性下疳主要在阴茎冠状沟、包皮内侧、包皮边缘、龟头、尿道外口;女性主要在大小阴唇、阴蒂、阴道口、阴道、子宫颈处。
梅毒疹出
在下疳出现7-8周后,便开始出现皮疹,分为早发性毒和复方性梅毒。早发性梅毒开始后常常会出现头痛、头晕、低热、全身不适、关节骨骼酸痛、食欲不振等症状。头痛、骨骼酸痛常表现为弥漫性、以夜间尤为明显。发热的温度一般在38℃左右。这些症状的出现是由于机体对螺旋体散步全身的一种全身性反应,皮疹出现2-3后可能会自行消退,多在2年内便开始复发。
扁平湿疣
扁平湿疣是二期梅毒的常见症状之一,所谓扁平湿疣是指好发于外生殖器、肛门、股内侧、乳房下方的皮肤褶皱及多汗出部位的丘疹,如果有大量液体渗出便称之为湿性丘疹。当湿性丘疹扩大增高或互相融合后,便形成肥厚性斑块,以表面扁平而又糜烂、基底阔广、触之坚硬、有触痛及牙痛感、分泌物有臭味为主要特点。
黏膜病变
黏膜会出现卡他炎症,即表现为口唇、咽部糜烂性发红、微肿、干痛、声音嘶哑、失音,严重出现糜烂和少量渗出;粘膜斑表面有白色薄膜覆盖,斑周无红晕、不痛、含有许多螺旋体。
秃发病变
20%的梅毒患者会有秃发的表现,常见细小圆形、椭圆形脱发斑片,大多数在1cm之内。一般分布在头顶附近,病变部位与正常部位边界不清,呈虫蛀咬状,梅毒治疗后,头发便可再生。
骨关节病变
75%的梅毒患者在梅毒二期时会出现骨关节损害、骨膜炎等症状。在长骨胫腓骨、尺桡骨、扁骨中颅、跟骨、肩胛骨脊常表现为骨部疼痛、夜间尤甚,X线检查可见骨膜轻度增厚及隆起;在肩、肘、膝、踝关节处表现为对成型肿胀、疼痛、关节腔积液,夜间加重,运动减轻,压痛、酸痛明显为主要特点;其他的换魔焰、腱鞘炎、骨炎较为少见。
眼梅毒病变
在眼睛检查时可见虹膜睫状体炎、脉络膜炎、视网膜炎、虹膜炎等疾病。常表现为视物不清、虹膜充血、肿胀、组织纹理消失、瞳孔不规则,呈现出褐色。
神经梅毒病变
神经梅毒大多数没有明显症状,当脑脊液检查呈阳性时,可见脑膜炎症、惊厥、失语等症状。





